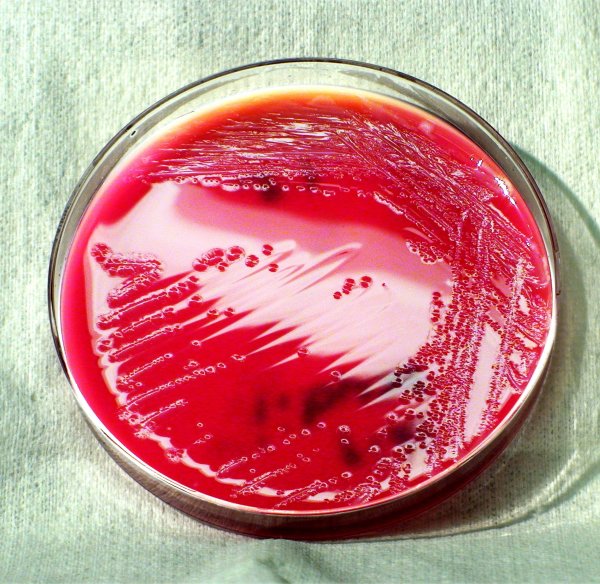
Бактерии рода шигелла

картинки шигеллы
Коллекция качественных и уникальных картинок с изображениями шигеллы - бактерии, вызывающей воспалительные заболевания пищеварительной системы. Подробные и яркие изображения помогут визуализировать внешний вид и строение шигеллы, а также иллюстрировать ее патогенные свойства. Найдите нужные графические материалы для научных и образовательных целей.

Возбудитель дизентерии Shigella dysenteriae

Строение шигеллы микробиология

Палочка шигеллы

Шигелла дизентерийная

Шигеллы токсинообразование

Бактерии рода шигелла

Шигелла Флекснера морфология

Возбудитель дизентерии Shigella dysenteriae

Бактерии рода шигелла

Шигеллез возбудитель микробиология

Дизентерии (Shigella dysenteriae)

Микроскопия кала лейкоциты

Возбудитель дизентерии Shigella dysenteriae
Бактерии рода шигелла

Дизентерия шигеллез возбудитель

Дизентерийная палочка шигелла

Характеристика возбудителя дизентерии шигелл

Бактерии шигеллы

Возбудитель дизентерии микробиология

Shigella dysenteriae (шигелла дизентерия)

Бацилла шигелла

Shigella dysenteriae (шигелла дизентерия)

Шигелла дизентерия

Дизентерия шигеллез сальмонеллез

Shigella dysenteriae (шигелла дизентерия)

Шигелла жгутики

Бацилла шигелла

Бактерии рода шигелла

Shigella dysenteriae микроскопия

Шигеллез возбудитель

Шигелла дизентерия

Бактерии шигеллы

Кишечная палочка дизентерия

Шигелла Флекснера

Шигелла Григорьева Шига

Дизентерийная палочка шигелла

Бактерия шигелла

Бактерии рода шигелла

Бактерии шигеллы

Шигелла Флекснера

Бактериальная дизентерия шигеллез

Возбудитель дизентерии Флекснера

Шигеллез возбудитель микробиология

Шигелла дизентерия

Возбудители бактериальной дизентерии

Бактерия шигелла
Комментировать
Комментарии (0)
Смотрите онлайн или можете скачать на телефон или компьютер в хорошем качестве совешенно бесплатно. Не забывайте оставить комментарий и посмотреть другие фотографии и изображения высокого качества, например наутилус картинки и бактерии картинки микробиология из раздела Картинки для срисовки













 Grizly.club
Grizly.club

